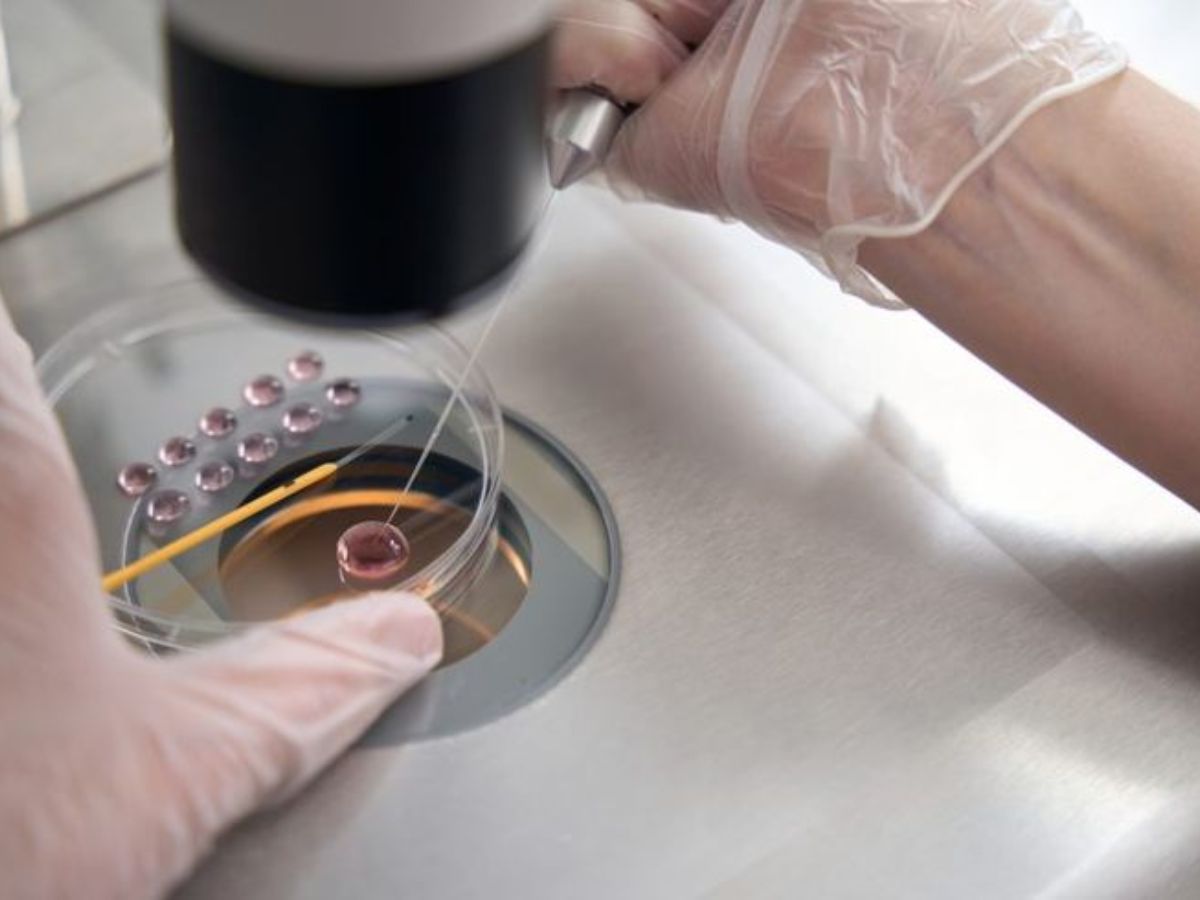
Is Delayed Marriage Driving This Trend? - Photo Gallery

35-40 के बाद मां बनना कितना सुरक्षित? Daisy Shah के एग फ्रीजिंग खुलासे ने तोड़े मिथ! जानें उम्र, खर्च, स्टोरेज लिमिट और सक्सेस रेट
बदलती लाइफस्टाइल के बीच एग फ्रीजिंग एक मॉडर्न फर्टिलिटी ऑप्शन के तौर पर लोगों का ध्यान खींच रहा है. डेज़ी शाह के खुलासे ने इस प्रोसेस से जुड़ी उम्र, मेडिकल फैक्टर्स और असल उम्मीदों को समझने की जरूरत पर जोर दिया है.

What Is Egg Freezing
एग फ्रीजिंग (मेडिकल भाषा में इसे oocyte cryopreservation कहते हैं) एक प्रोसेस है जिसमें एक महिला के एग्स को IVF के जरिए इकट्ठा किया जाता है, फ्रीज किया जाता है और आगे की प्रेग्नेंसी के लिए स्टोर किया जाता है. डेज़ी शाह के इस खुलासे ने लोगों का ध्यान खींचा कि उन्होंने अपने एग्स फ्रीज करवाए थे, जिससे फर्टिलिटी ऑप्शन के बारे में पूरे देश में बातचीत शुरू हो गई.

Ideal Age to Freeze Eggs
डॉक्टरों का कहना है कि एग्स फ्रीज करने की सबसे अच्छी उम्र 35 साल से पहले है, बेहतर होगा कि 20s के आखिर में या 30s की शुरुआत में क्योंकि उम्र के साथ एग की क्वालिटी और क्वांटिटी कम हो जाती है. कम उम्र में फ्रीज किए गए एग से बाद में प्रेग्नेंसी होने की संभावना ज़्यादा होती है.

Success Rates After 35 or 40 – The Reality
एग फ्रीजिंग प्रेग्नेंसी की गारंटी नहीं देता है.
अगर एग्स 35 से पहले फ्रीज किए जाते हैं, तो सक्सेस रेट काफी ज़्यादा होता है.
35 के बाद, चांस कम हो जाते हैं.
40 के बाद सक्सेस रेट तेजी से कम हो जाता है और ज्यादा एग्स की जरूरत होती है. आप किस उम्र में फ्रीज करवाते हैं यह प्रेग्नेंट होने की उम्र से ज्यादा जरूरी है.

Cost of Egg Freezing in India
इंडिया में हर साइकिल का खर्च आम तौर पर ₹1.2 लाख से ₹3 लाख के बीच होता है.
एक्स्ट्रा सालाना स्टोरेज फीस ₹10,000–₹50,000 तक हो सकती है.
आगे IVF ट्रीटमेंट का खर्च अलग है और फ्रीजिंग फीस में शामिल नहीं है.

Storage Limits – How Long Eggs Can Be Frozen
फ्रोज किए गए एग्स को कई सालों (अक्सर 10+ साल) तक बिना क्वालिटी खराब हुए सुरक्षित रूप से स्टोर किया जा सकता है जब तक कि सही मेडिकल स्टोरेज कंडीशन बनाए रखी जाएं. इसकी कोई एक्सपायरी डेट नहीं है, लेकिन क्लिनिक के नियम और इंडियन रेगुलेशन लागू होते हैं.

Who Should Consider Egg Freezing
एग फ्रीजिंग इनके लिए सही हो सकती है:
जो महिलाएं शादी या पेरेंट बनने में देरी कर रही हैं.
जो करियर या पढ़ाई पर फोकस कर रही हैं.
जिन महिलाओं को मेडिकल कंडीशन हैं या जिनके इलाज से फर्टिलिटी पर असर पड़ रहा है.
जो लोग रिप्रोडक्टिव कंट्रोल चाहते हैं जैसा कि डेज़ी शाह ने खुलकर कहा है.
Is Delayed Marriage Driving This Trend?
हां, एक्सपर्ट्स का कहना है कि देर से शादी, करियर की प्राथमिकताएं और बदलते सोशल नॉर्म्स एग फ्रीजिंग में बढ़ती दिलचस्पी के मुख्य कारण हैं. सेलिब्रिटी के खुलेपन ने भी स्टिग्मा कम किया है और जागरूकता बढ़ाई है.

Common Myths vs Medical Reality
मिथ: एग फ्रीजिंग प्रेग्नेंसी की गारंटी देता है
असलियत: यह सिर्फ चांस बढ़ाता है गारंटी नहीं देता
मिथ: आप किसी भी उम्र में एग फ्रीज कर सकते हैं
असलियत: कम उम्र के एग = बेहतर रिजल्ट
मिथ: एक साइकिल काफी है
असलियत: ज्यादा एग का मतलब आमतौर पर बाद में बेहतर सफलता होता है












